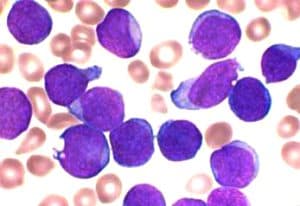
acute_lymphoblastic_leukaemia_smear

Time to find and develop your ‘Eureka!’ people
pharmafile | June 11, 2009 | Feature | Business Services |Â Â diversity, recruitment, trainingÂ
The big pharma model is broken, and one of the ways drug development companies are going to fix it is by changing they way they recruit and select people. Of course I would say that, I'm a recruiter, but hear me out!
I believe that today's companies, whether they be big pharma, telecoms, transport or any other industry, have got to start doing things differently, and that must begin with their people.
More specifically, I think companies need to find a way to select and develop 'eureka' people – staff who bring all their knowledge and experience to the table, not just that gained in their work, and use it to spark new ideas, find new ways of doing things, and to, dare I say it, think outside the box.
Click here to read the article in full on InPharm.com.
Related Content

Amgen donate $2m towards increasing diversity in clinical trials
American multinational Amgen has teamed up with the Lazarex Cancer Foundation in support of an …
New $2 million programme aims at increasing diversity in cancer research
The National Cancer Institute are developing a joint cancer drug discovery and development, and research …

FDA recruitment official says Trump’s policies are making hiring difficult
Melanie Keller, Acting Associate Commissioner for Scientific and Clinical Recruitment at the US Food and …






